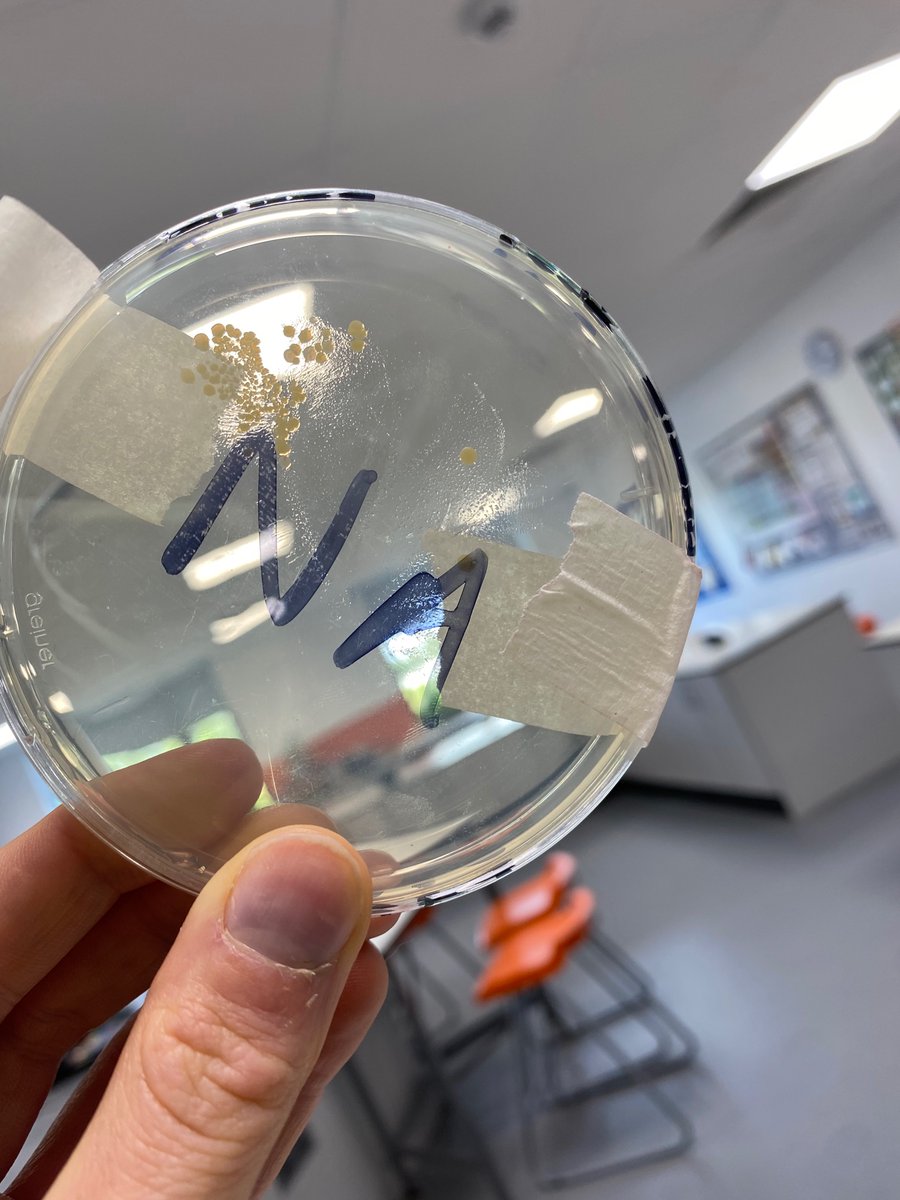
This is your sign to do agar leaf prints the next time you teach plant disease 🧫 🍃 Nutrient agar shown, potato dextrose might be worth a try! <a href="/PontSci/">Ponteland Science</a> <a href="/chatbiology/">Chat Biology</a>

Rachelle Falloon
@rachfalloon
Middle distance runner for Morpeth Harriers, former Light Blue.
ID: 549960707
10-04-2012 09:29:03
381 Tweet
250 Takipçi
259 Takip Edilen

This is your sign to do agar leaf prints the next time you teach plant disease 🧫 🍃 Nutrient agar shown, potato dextrose might be worth a try! Ponteland Science Chat Biology

Great team wins for U17 boys and both Senior Men and Women at Wrekenton NEHL yesterday, with Ewan Line winning U13s and Matthew Walton 1st in Senior Men. Super support - from humans and canines alike! #nehl Start Fitness




Busy weekend of action for Morpeth Harriers including TCS London Marathon and some great performances at the Kielder Marathon weekend where Mark Snowball and Rachelle Falloon were winners in the 10k












❗Attention Tyne & Wear schools❗ Our staff and students are coming to the Tyne & Wear area from 8-12 January to talk to state school pupils about applying to Cambridge. If you would like your school to receive a visit, please email [email protected] #NorthEast #Schools










